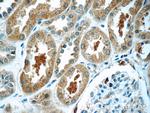
TXNDC16 Antibody in Immunohistochemistry (Paraffin) (IHC (P))

Search
Proteintech
TXNDC16 Polyclonal Antibody
{{$productOrderCtrl.translations['antibody.pdp.commerceCard.promotion.promotions']}}
{{$productOrderCtrl.translations['antibody.pdp.commerceCard.promotion.viewpromo']}}
{{$productOrderCtrl.translations['antibody.pdp.commerceCard.promotion.promocode']}}: {{promo.promoCode}} {{promo.promoTitle}} {{promo.promoDescription}}. {{$productOrderCtrl.translations['antibody.pdp.commerceCard.promotion.learnmore']}}
产品信息
21502-1-AP
种属反应
宿主/亚型
分类
类型
抗原
偶联物
形式
浓度
规格
纯化类型
保存液
内含物
保存条件
运输条件
产品详细信息
Immunogen sequence: PVSYAGMLG TEDLLKFIQL NRISYPVNIT SIQEAEEYLS GELYKDLILY SSVSVLGLFS PTMKTAKEDF SEAGNYLKGY VITGIYSEED VLLLSTKYAA SLPALLLARH TEGKIESIPL ASTHAQDIVQ IITDALLEMF PEITVENLPS YFRLQKPLLI LFSDGTVNPQ YKKAILTLVK QKYLDSFTPC WLNLKNTPVG RGILRAYFDP LPPLPLLVLV NLHSGGQVFA FPSDQAIIEE NLVLWLKKLE AGLENHITIL PAQEWKPPLP AYDFLSMIDA ATSQRGTRKV PKCMKETDVQ ENDKEQHEDK SAVRKEPIET LRIKHWNRSN WFKEAEKSFR RDKELGCSKV N (476-825 aa encoded by BC142650)
靶标信息
TXNDC16 gene ontology annotations related to this gene include cell redox homeostasis.
仅用于科研。不用于诊断过程。未经明确授权不得转售。
篇参考文献 (0)
生物信息学
蛋白别名: Thioredoxin domain-containing protein 16; unnamed protein product
基因别名: ERP90; KIAA1344; TXNDC16
UniProt ID: (Human) Q9P2K2
Entrez Gene ID: (Human) 57544